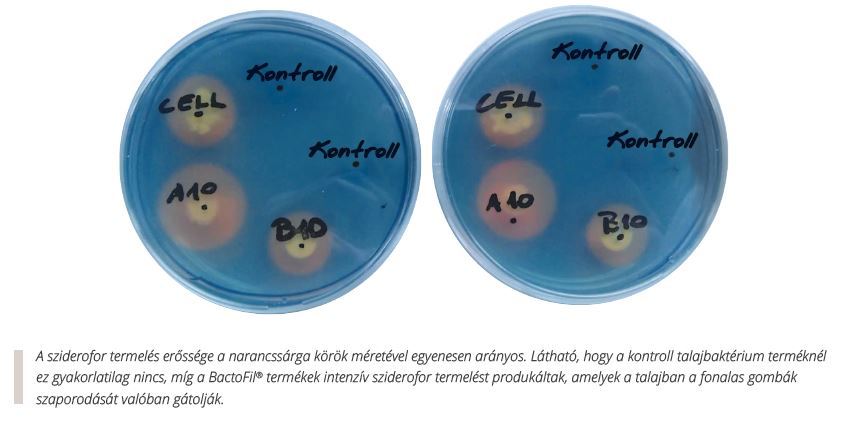

BactoFil A 10 prašek Lawn 10 g
| 3,59 € * (nettó: 2,83 €) | |
Opis BactoFil A 10 Powder Lawn:
DOBAVA NITROGENOV - Zagotavljanje razpoložljivih hranil
Izdelki BactoFil® vežejo dušik iz zraka v poroznih plasteh strukture tal in ga shranjujejo v vodi za dobrotopne amonijeve ione v vodi, zaradi česar so ti na voljo za sprejem rastlinam.Dušik, vezan v mineralni obliki v tleh in v organski obliki v razkrajajočih se rastlinskih ostankih, se nato uporabi zafosfor, kalij ter številni mezo- in mikroelementi v organski obliki v tleh v netopne oblike. Dodatna prednost inokulacije tal je, da se znatno izboljša tudi izkoristek uporabljenih gnojil.

Rezultat: zaradi bolj usklajene oskrbe s hranili in večje količine hranil se poveča živa masa rastlin in izboljša njihova hranilna vrednost.
Učinek biokontrole:
Z uporabo izdelkov BactoFil® se znatno zmanjša število patogenov v tleh. Bakterijski sevi v izdelkih razgrajujejo patogenek életterét és tápanyagforrását jelentő növénymaradványokat. U. siderofori, ki jih proizvajajo bakterije, vežejo železove ione (Fe+++) in proizvajajo snovi (antibiotike), ki zavirajo rast patogenov (npr. bakterij, gliv itd.). Fusarium), kar lahko znatno zmanjša pritisk okužb, ki se prenašajo s tlemi.
Rezultat: bolj zdravo okolje korenin (rizosfera), v katerem se v odsotnosti železovih ionov (Fe+++) bistveno zmanjša infekcijski potencial patogenih organizmov.
HORMONSKA PRODUKCIJA - proizvodnja biološko aktivnih snovi
Talne bakterije v pripravkih BactoFil® sintetizirajo hormone (avksin, giberelin, citokin). Ti hormoni močno spodbujajo kalitev ter hiter in enakomeren vznik. Rastline razvijejo globok in gost koreninski sistem, jesenski posevki pa postanejo bolj odporni proti zmrzali in pozebi. Povečanje zimske odpornosti na ta način je še posebej pomembno za pozne jesenske setve. Za rastlino je koreninska masa odločilni dejavnik pri uravnavanju individualnega razvoja, kar pomeni, da ustrezno prilagodi svojo nadzemno rast. Razvoj začetnega koreninskega sistema je glavni dejavnik pridelka. Poleg hormonov se sintetizirajo tudi druge organske snovi, vitamini, aminokisline in organske kisline.
Učinek sredstva BactoFil A10 je viden že v zgodnjem razvoju pšenice. Dolžina korenin se lahko znatno poveča pred pozebo, masa korenin pa po pozebi (Nemčija, jesen 2016 - pomlad 2017).
Rezultat: povečana površina korenin poveča vnos vode in hranil v rastline ter zagotavlja boljšo vzdržljivost.
Izboljšanje strukture tal
Za razvoj dobrih tal so potrebna stoletja, vendar se lahko tudi najboljša tla v nekaj letih močno poslabšajo. Poleg fizične in kemične degradacije tla vsebujejo le desetino koristnih talnih bakterij, kot jih potrebujejo.
Izguba koristnih talnih bakterij se kaže tudi v tem, da se rastlinski ostanki v tleh veliko počasneje razgrajujejo. Dva temelja zgornje plasti tal sta vsebnost humusa in struktura tal. V zbitih tleh ni dovolj zraka in rast koristnih talnih bakterij se upočasni.
Uporaba izdelkov BactoFil® že po dveh do treh letih jasno izboljša strukturo tal. Eksopolisaharidi (EPS), ki jih proizvajajo nekateri bakterijski sevi (npr. Micrococcus roseus) (1. (slika 1) delujejo kot vezivo med posameznimi delci tal (slika 2). Tako iz osnovnih delcev zgrajena zemlja ima več por ter bolje zadržuje toploto in vodo.
Rezultat:Izboljšana struktura tal v smislu obdelovalnosti (manjša poraba goriva), zmanjšanje škode zaradi ekstremnih vremenskih razmerizboljšano zadrževanje vode v tleh, boljše stanje pridelkov in pridelka.
Sestava seva BactoFil® A 10:

| Teža: | 0.01 kg |
|---|---|
| Širina: | 80 mm |
| Višina: | 130 mm |
| Dolžina: | 20 mm |
| Osnovna prodajna enota: | db |
| Rastlinska kultura: | Bio, Travnik |
| Razpoložljivost izdelka: | 1-4 dni |
Prijava
Prijava

